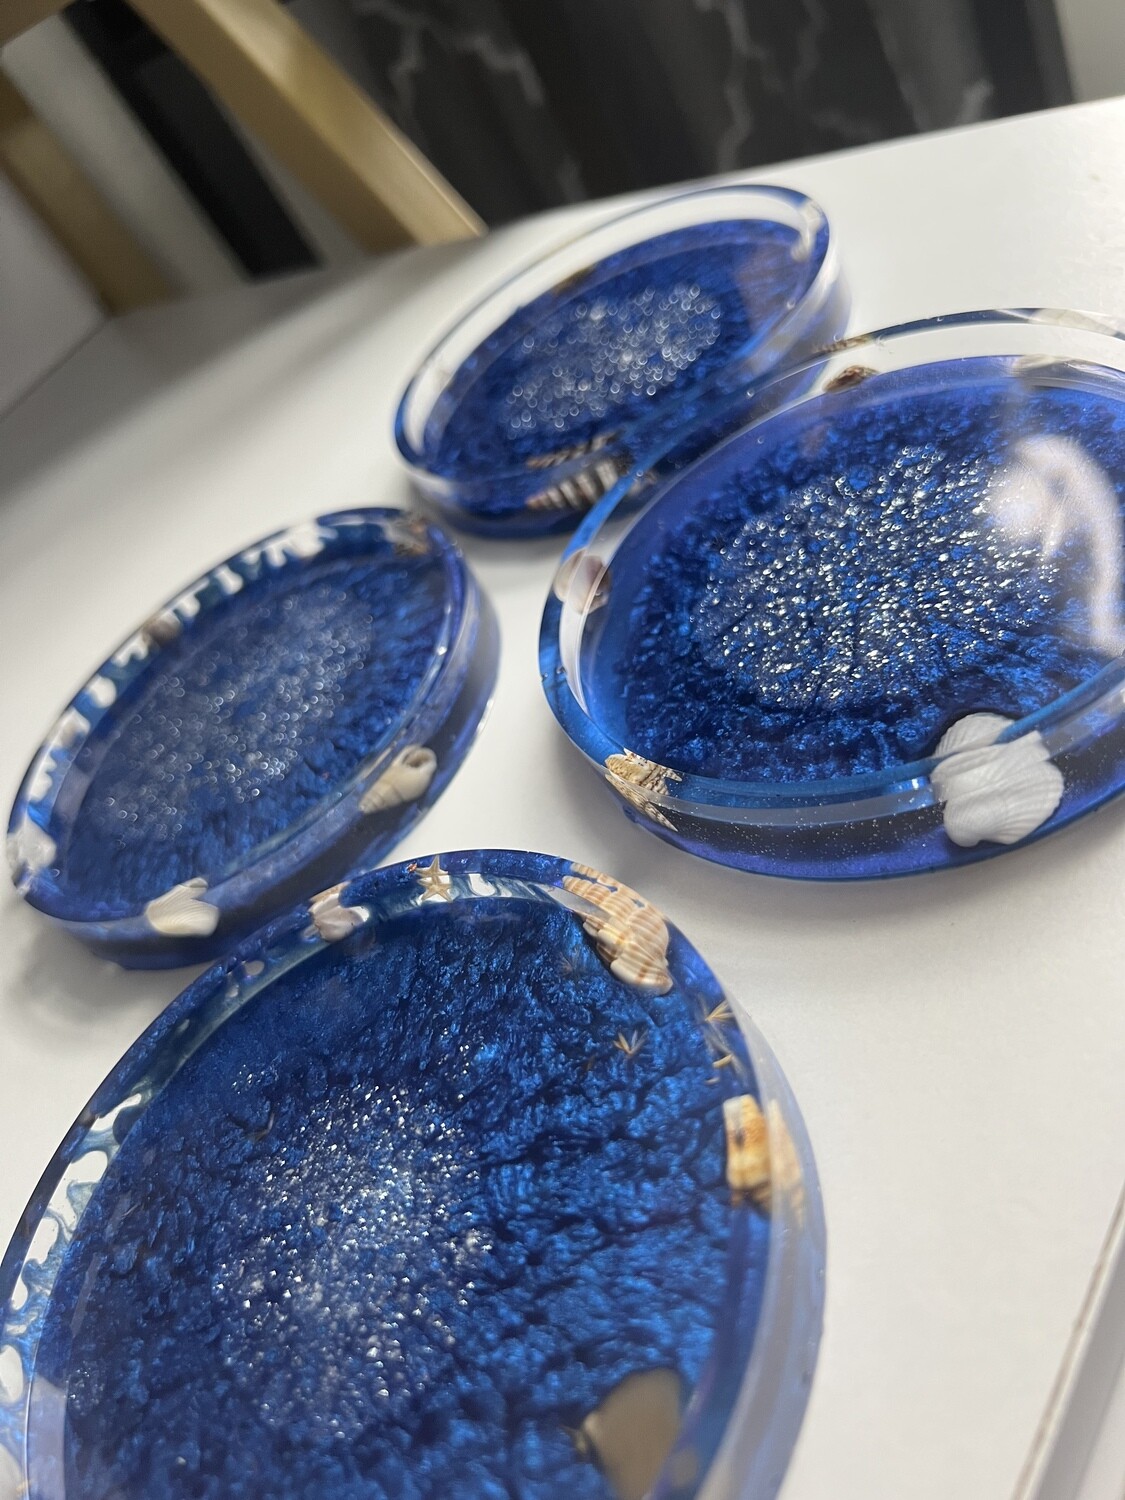

Creations by Colette
Customizable resin art 🦋
Free US shipping over $50.
Coasters with side wall
Customize your collectibles with these resin coasters. Available in a variety of colors and themes, these pieces will look amazing on your dining table, coffee table, desk, etc. Pick your flowers and colors or send a few flowers from your wedding bouquet. Personalize your living space to include beautiful sentimental keepsakes from special moments in your life.
About Us

Colette Donnelly
store owner
Local to Connecticut, Creations by Colette is owned by Colette Donnelly; a lover of creation therapy and various mediums of art. This small business prides itself on community involvement and fair pricing. The roots of Creations by Colette started when Colette wanted to make meaningful wedding presents for friends. She began learning how to dry and press flowers, worked with resin (with lots of trial and error) and discovered a passion for memorializing special moments. Now, as a creative outlet for her full-time job in Victim Services, she makes curated pieces that bring individuality and beauty to your home! Thank you for the continued support 🦋
Based in CT. Local pick up available. Follow @creations_by_colette on Instagram for local pop up event information ✨
Email creations.by.colette22@gmail.com for custom order inquiries 💐